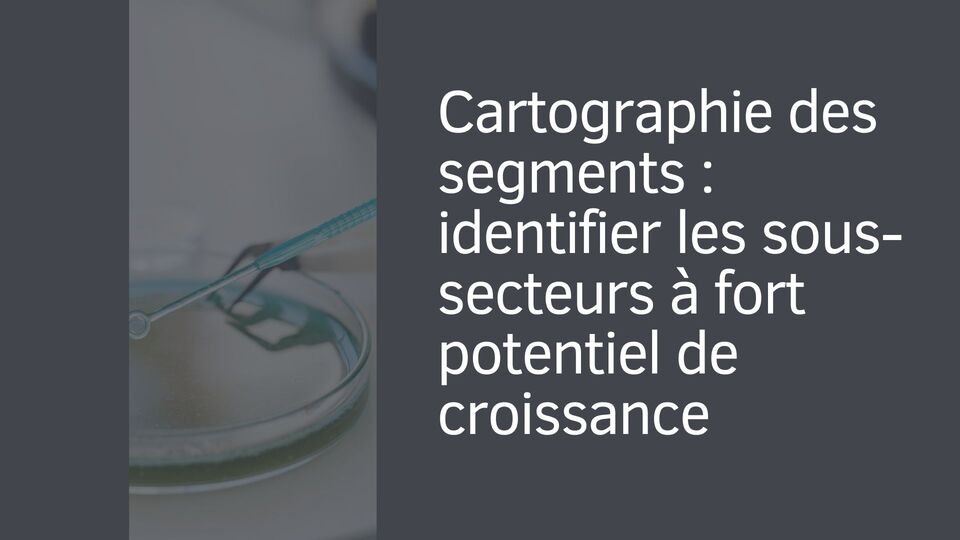
Cartographie des segments : identifier les sous-secteurs à fort potentiel de croissance

Le secteur des biotechnologies et de la santé chinois traverse une métamorphose historique. Avec des investissements gouvernementaux de 42 milliards d’euros en 2025 et une croissance annuelle moyenne de 18%, cette industrie représente aujourd’hui l’opportunité d’investissement la plus prometteuse dans le domaine des sciences de la vie.
Face à cette révolution biotechnologique, vous vous interrogez peut-être sur les véritables opportunités disponibles, les entreprises leaders à privilégier et les risques inhérents à ce secteur en pleine ébullition. Cette préoccupation est parfaitement légitime : investir dans les biotechnologies demande une compréhension approfondie des dynamiques scientifiques, réglementaires et commerciales complexes.
Cet article vous accompagne dans cette démarche d’investissement stratégique, en analysant méthodiquement les acteurs clés, les segments porteurs et les critères décisionnels pour construire un portefeuille biotechnologique chinois performant et diversifié dans cette industrie d’avenir.
Retrouvez le podcast de cet article ci-dessous :
Cet article est un guide à but purement informatif et ne constitue en aucun cas un conseil en investissement financier. Le secteur des biotechnologies chinoises est particulièrement volatil et présente des risques spécifiques élevés, incluant la perte totale du capital. Il est indispensable de mener vos propres recherches approfondies et de consulter un conseiller financier professionnel avant de prendre toute décision d’investissement.
N’hésitez pas à me contacter pour en savoir plus.
Sommaire
Le contexte macroéconomique : la Chine, future superpuissance biotechnologique mondiale

La montée en puissance de la Chine dans les biotechnologies ne relève pas du hasard, mais d’une stratégie gouvernementale coordonnée et ambitieuse. Le plan « 十四五 »国民健康规划 (Plan national de santé du 14e plan quinquennal) positionne les biotechnologies comme secteur stratégique prioritaire, avec des objectifs de transformation qui redéfinissent les standards mondiaux.
Cette vision politique se matérialise par des investissements colossaux : 42 milliards d’euros mobilisés annuellement depuis 2025, répartis entre innovation pharmaceutique (35%), équipements médicaux haute technologie (25%), médecine de précision (20%), médecine régénérative (12%) et biomanufacturing (8%). Cette approche diversifiée garantit un développement harmonieux de l’écosystème biotechnologique.
L’objectif d’atteindre 674 milliards d’euros de marché total d’ici 2030 révèle l’ampleur de la transformation en cours. Cette croissance s’accompagne d’une montée en gamme technologique spectaculaire : la Chine ne se contente plus d’imiter, elle innove et développe des thérapies révolutionnaires comme les CAR-T, positionnant certaines entreprises chinoises en leaders mondiaux.
Le marché domestique chinois, avec sa population vieillissante de 1,4 milliard d’habitants, offre aux entreprises locales un laboratoire d’envergure unique pour tester et valider leurs innovations thérapeutiques. Cette base démographique solide permet ensuite une expansion internationale avec des solutions éprouvées, créant un cercle vertueux de croissance et d’innovation.

Évolution du marché chinois biotechnologies/santé par segment 2020-2030 (milliards d’euros)
Données clés du secteur biotechnologies/santé :

La Chine représente déjà le second marché mondial des biotechnologies avec 32% de part de marché. Le vieillissement rapide de sa population (28% de plus de 60 ans d’ici 2030) crée une demande structurelle massive pour les innovations thérapeutiques.
Cartographie des segments : identifier les sous-secteurs à fort potentiel de croissance
Le secteur biotechnologique chinois se structure autour de six segments principaux, chacun présentant des caractéristiques d’investissement distinctes et des perspectives de rendement différenciées. Cette segmentation vous permet d’optimiser votre allocation en fonction de votre profil de risque et vos objectifs temporels.
L’innovation pharmaceutique constitue le segment le plus mature et le plus volumineux, représentant 168,8 milliards d’euros en 2025 avec une croissance stable de 12-15% annuelle. Ce segment inclut les thérapies oncologiques de pointe développées par BeiGene, les médicaments biologiques innovants et les biosimilaires. Sa maturité relative offre une visibilité financière rassurante pour les investisseurs prudents.
Les équipements médicaux haute technologie connaissent une expansion remarquable (126,6 milliards d’euros, +18-22% annuel), portée par la politique « China Manufacturing 2025 » et l’essor des hôpitaux privés. Mindray domine ce segment avec ses solutions d’imagerie médicale et de monitoring patients, tandis que de nouveaux acteurs émergent dans la robotique chirurgicale et l’IA médicale.
Les services de diagnostic et CRO représentent le segment à plus forte croissance (84,4 milliards d’euros, +25-30% annuel), tiré par la globalisation de la R&D et l’outsourcing croissant des essais cliniques. WuXi AppTec domine cette niche avec ses services intégrés couvrant l’ensemble de la chaîne de développement pharmaceutique.
La médecine de précision et génomique (25,3 milliards d’euros, +35-45% annuel) bénéficie de l’essor du séquençage génétique et de la médecine personnalisée. BGI s’impose comme leader mondial du séquençage à grande échelle, ouvrant la voie à des applications thérapeutiques révolutionnaires.

Répartition des investissements gouvernementaux chinois en biotechnologies/santé (2025)
Répartition par segment et potentiel de croissance :

Les segments à plus forte croissance (médecine de précision, thérapies cellulaires) présentent également une volatilité plus élevée. Une allocation diversifiée permet de capter le potentiel tout en lissant les risques sectoriels spécifiques.
Analyse des entreprises établies : stabilité financière et perspectives d’expansion

Les entreprises établies du secteur biotechnologique chinois offrent une combinaison unique de solidité financière et de potentiel de croissance international. Leur analyse révèle des profils d’investissement complémentaires, adaptés à différentes stratégies patrimoniales.
Sinopharm domine le paysage avec 69,2 milliards d’euros de chiffre d’affaires en 2025, consolidant sa position de géant de la distribution pharmaceutique chinoise. En tant qu’entreprise d’État, elle bénéficie d’un accès privilégié au marché domestique et d’un soutien gouvernemental constant. Sa croissance modérée (4,8% annuel) reflète la maturité de ses activités de distribution, mais ses investissements en R&D ouvrent de nouvelles perspectives dans l’innovation pharmaceutique.
Mindray représente l’excellence technologique chinoise avec 48,2 milliards d’euros de revenus et une croissance soutenue de 15% annuelle. L’entreprise a réussi sa transition d’assembleur vers innovateur, développant des équipements médicaux rivalisant avec les standards européens et américains. Sa stratégie d’expansion internationale porte ses fruits avec une présence croissante dans les hôpitaux haut de gamme mondiaux.
WuXi AppTec incarne le succès de la spécialisation avec 58,9 milliards d’euros de chiffre d’affaires et une croissance exceptionnelle de 20,6% annuelle. Leader mondial des services CRO/CDMO, l’entreprise capitalise sur la tendance à l’externalisation de la R&D pharmaceutique. Son modèle CRDMO intégrant recherche, développement et production offre une valeur ajoutée unique aux laboratoires pharmaceutiques globaux.
La qualité des pipelines R&D de ces entreprises constitue un avantage concurrentiel durable. WuXi AppTec investit 12,5% de son chiffre d’affaires en R&D, Mindray 10,8%, positionnant ces entreprises pour capturer les prochaines vagues d’innovation.

Performance comparative des leaders établis biotechnologies/santé chinois (2025)
Performance financière comparative 2025 :

Ces entreprises établies bénéficient d’une reconnaissance internationale croissante et d’accès privilégié aux marchés développés. Leurs valorisations restent attractives comparées aux équivalents occidentaux, offrant un potentiel de réévaluation significatif.
Les pépites émergentes : innovation disruptive et opportunités de croissance explosive

Les entreprises émergentes du secteur biotechnologique chinois incarnent l’innovation de rupture, offrant des potentiels de rendement exceptionnels accompagnés naturellement de risques plus élevés. Leur évaluation nécessite une approche spécialisée combinant analyse scientifique et due diligence financière rigoureuse.
BeiGene se positionne comme la success story par excellence des biotechnologies chinoises, avec 8,4 milliards d’euros de valorisation et une croissance explosive de 47,3% annuelle. L’entreprise a révolutionné l’oncologie avec ses inhibiteurs BTK et anti-PD-1, obtenant des approbations réglementaires simultanées en Chine, aux États-Unis et en Europe. Son pipeline de 66 molécules en développement couvre l’ensemble des cancers les plus fréquents.
BGI maintient sa position de leader mondial du séquençage génétique avec 1,2 milliard d’euros de revenus et 12,8% de croissance annuelle. L’entreprise a démocratisé l’accès au séquençage génétique en réduisant les coûts de 30 000 à moins de 100 dollars par génome. Ses applications s’étendent de la médecine de précision à l’agriculture, créant un écosystème technologique intégré unique au monde.
Gracell Biotech révolutionne la médecine avec ses thérapies CAR-T, affichant une croissance stratosphérique de 135% annuelle. Leader mondial des thérapies anti-BCMA pour le myélome multiple, l’entreprise développe des approches « in vivo » permettant de produire des CAR-T directement dans l’organisme du patient, éliminant les contraintes de production en laboratoire.
Ces entreprises bénéficient de partenariats stratégiques majeurs validant leurs technologies. BeiGene collabore avec des géants pharmaceutiques internationaux, BGI équipe des laboratoires dans plus de 100 pays, Gracell développe des technologies révolutionnaires de thérapies cellulaires de nouvelle génération.

Évaluation multi-critères des pépites émergentes biotechnologies chinoises
Profil d’innovation des pépites émergentes :

Ces entreprises émergentes nécessitent une approche de portfolio diversifié. Investir dans 4-6 entreprises de ce segment permet de capter les succès exceptionnels (rendements 10-100x possibles sur 10 ans) tout en diluant les risques d’échec inhérents à l’innovation de rupture.
Stratégies d’investissement : construire un portefeuille biotechnologique équilibré

La construction d’un portefeuille biotechnologique chinois optimal nécessite une approche méthodique intégrant diversification sectorielle, étalement temporel et gestion active des risques réglementaires. Cette stratégie vous permet de naviguer sereinement dans un secteur à fort potentiel mais intrinsèquement complexe.
L’allocation stratégique recommandée pour un investisseur européen s’articule autour de trois piliers : 50% dans les valeurs sûres (Sinopharm, Mindray, WuXi AppTec) pour la stabilité, 35% dans les entreprises en croissance (BeiGene, BGI) pour la performance, et 15% dans l’innovation pure (Gracell, startups thérapies avancées) pour le potentiel disruptif.

Stratégie d’allocation recommandée pour un portefeuille biotechnologies chinois
Cette répartition offre un équilibre optimal entre rendement espéré (15-25% annuel) et maîtrise du risque. Les valeurs sûres apportent des dividendes réguliers et une protection contre la volatilité, les entreprises en croissance captent l’expansion du marché chinois, et les positions d’innovation offrent une exposition aux révolutions thérapeutiques.
La dimension temporelle revêt une importance cruciale dans les biotechnologies. Un horizon d’investissement de 8-12 ans permet de traverser les cycles de développement clinique, essentiels pour la maturation des innovations thérapeutiques. Les investissements à court terme (moins de 5 ans) exposent à une volatilité excessive liée aux résultats d’essais cliniques et aux décisions réglementaires.
La diversification géographique au sein de l’écosystème chinois mérite attention. Les entreprises de Shanghai (WuXi AppTec, BeiGene) bénéficient de l’expertise financière internationale, celles de Pékin (Sinopharm, BGI) profitent de la proximité avec les régulateurs, tandis que Shenzhen (Mindray, Gracell) capitalise sur l’innovation technologique.
Modèle d’allocation recommandé :

Le secteur biotechnologique chinois présente une corrélation modérée avec les marchés occidentaux (0,6), offrant une diversification géographique intéressante. L’exposition aux risques de change yuan/euro peut être couverte par des swaps de devises.

Investir dans les biotechnologies chinoises implique de naviguer entre des opportunités exceptionnelles et des risques géopolitiques spécifiques qu’il convient d’identifier et de quantifier précisément. Cette analyse prospective vous permet d’ajuster votre stratégie en fonction de l’évolution du contexte international et réglementaire.
Le vieillissement démographique chinois constitue l’opportunité structurelle majeure du secteur. Avec 400 millions de personnes âgées de plus de 60 ans d’ici 2030, la Chine fait face à une demande thérapeutique sans précédent historique. Cette transition démographique irréversible garantit une croissance soutenue indépendamment des fluctuations économiques cycliques, particulièrement pour les thérapies oncologiques, cardiovasculaires et neurodégénératives.
Les tensions géopolitiques sino-américaines représentent le principal risque systémique du secteur. Les restrictions américaines sur les biotechnologies chinoises (interdiction d’accès aux bases de données NIH, limitations sur les essais cliniques) impactent directement les stratégies de développement international. Cependant, ces contraintes stimulent paradoxalement l’innovation domestique chinoise et accélèrent l’indépendance technologique.
L’innovation en thérapies cellulaires CAR-T offre une opportunité disruptive majeure, mais s’accompagne de risques technologiques élevés. La Chine compte 388 centres de recherche CAR-T sur les 2069 mondiaux, positionnant le pays comme second écosystème mondial. Cette concentration d’expertise crée des synergies uniques mais expose également à une volatilité réglementaire spécifique.
La politique de santé domestique chinoise génère des opportunités massives d’expansion. Le plan national d’assurance maladie couvre désormais 95% de la population, créant un marché solvable de 1,4 milliard de patients. Cette universalisation de l’accès aux soins stimule la demande pour les innovations thérapeutiques de pointe.

Matrice risques/opportunités du secteur biotechnologies/santé chinois
Évaluation des facteurs critiques :

Les risques géopolitiques, bien que réels, ne remettent pas en question les fondamentaux de croissance démographique et d’innovation. Une approche diversifiée et un horizon approprié permettent de traverser ces turbulences temporaires tout en captant le potentiel de long terme.
Conclusion

Le secteur biotechnologique chinois traverse une phase de transformation historique, portée par une convergence unique de soutien gouvernemental, d’innovation scientifique de pointe et de demande démographique structurelle. Cette dynamique crée des opportunités d’investissement exceptionnelles pour les investisseurs capables de naviguer dans cet écosystème sophistiqué.
L’analyse des entreprises établies (Sinopharm, Mindray, WuXi AppTec) et émergentes (BeiGene, BGI, Gracell) révèle un secteur en pleine maturation, où coexistent stabilité financière et potentiel de croissance disruptive. La construction d’un portefeuille équilibré, intégrant ces différents profils de risque, permet de capter cette dynamique tout en maîtrisant la complexité inhérente aux biotechnologies.
Les défis géopolitiques et réglementaires, bien que significatifs, ne remettent pas en question les moteurs fondamentaux de croissance à long terme. Le vieillissement démographique chinois et les révolutions thérapeutiques en cours créent une demande structurelle qui soutiendra le secteur au-delà des fluctuations géopolitiques temporaires.

FAQ – Questions fréquentes

Q : Les tensions géopolitiques menacent-elles réellement les investissements biotechnologiques chinois ?
R : Les restrictions créent des défis à court terme mais stimulent l’indépendance technologique chinoise. Une diversification géographique limite l’exposition aux risques géopolitiques spécifiques.
Q : Quel horizon d’investissement recommandez-vous pour les biotechnologies ?
R : 8-12 ans minimum pour traverser les cycles de développement clinique et réglementaire. Les biotechnologies nécessitent patience et vision long terme pour optimiser les rendements.
Q : Comment évaluer les entreprises biotechnologiques sans expertise médicale ?
R : Focus sur les partenariats internationaux, les approbations réglementaires obtenues, la solidité des équipes scientifiques et la validation commerciale plutôt que sur l’évaluation technique pure.
Q : Le marché biotechnologique chinois est-il accessible aux investisseurs européens ?
R : Oui, via les marchés de Hong Kong, les ADR américains, les fonds spécialisés et les investissements directs. Chaque option présente des avantages fiscaux et réglementaires spécifiques.
Pour optimiser votre stratégie d’investissement dans cet univers biotechnologique prometteur mais complexe, n’hésitez pas à me contacter pour bénéficier d’une analyse personnalisée de votre situation et développer ensemble une approche d’investissement adaptée à vos objectifs patrimoniaux et votre tolérance au risque.






